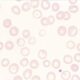
¿Cómo se manifiesta clínicamente la anemia megaloblástica?

Fuentes y requerimientos
El ácido fólico (pteroilglutámico) es una sustancia amarilla, cristalina e hidrosoluble. La mayor parte de los alimentos contienen algo de folato. Sin embargo, los que contienen mayores concentraciones son el hígado, la levadura, la espinaca, otros vegetales verdes y los granos.
El contenido total de folato de la alimentación occidental promedio es de unos 250 µg/ día, pero la cantidad varía con el tipo de alimento que se consume y el método de cocción. El folato se destruye con facilidad por el calentamiento, en especial con agua abundante.
El folato total del organismo en el adulto es de alrededor de 10 mg y el hígado es el órgano que contiene la reserva más abundante. Las necesidades diarias de folato en el adulto son de cerca de 100 µg, de manera que las reservas bastan sólo para tres o cuatro meses en los adultos sanos antes de que ocurra una deficiencia rápida y grave.
Absorción por el organismo
Los folatos se absorben con rapidez en la porción superior del intestino delgado. En promedio se absorbe cerca de 50% del folato de los alimentos. Los poliglutamatos son hidrolizados hasta formar derivados de monoglutamato, ya sea en la luz intestinal o en la mucosa. Todos los folatos de los alimentos son convertidos en 5-metilTHF (5-MTHF) en la mucosa del intestino delgado antes de entrar en el plasma de la circulación portal.
Los monoglutamatos son transportados activamente a través del enterocito por un transportador de folato acoplado a protones, situado en el borde apical en cepillo, y con mayor actividad a pH de 5.5, que es aproximadamente el mismo que se encuentra en la luz duodenoyeyunal. Las dosis >400 µg de ácido pteriloglutámico se absorben casi sin cambios y se convierten en folato natural en el hígado. Las dosis menores se convierten en 5-MTHF durante su absorción intestinal.
Todos los días entran a la bilis alrededor de 60 a 90 µg de folato, que se excretan hacia el intestino delgado. La eliminación de este folato, junto con el de las células intestinales esfaceladas, acelera la rapidez con la cual sobreviene deficiencia de folato en los trastornos que se acompañan de una absorción deficiente.
Transporte
El folato se transporta en el plasma; alrededor de un tercio se une con debilidad a la albúmina y dos tercios se encuentran libres. En los líquidos corporales (plasma, líquido cefalorraquídeo, leche, bilis) casi todo el folato consta de 5-MTHF en forma de monoglutamato.
Intervienen tres tipos de proteínas fijadoras de folato. El elemento principal de transporte del folato plasmático a las células es el transportador de folato reducido. Dos receptores de folato, FR2 y FR3, dentro de la membrana celular, fijados por el elemento de anclaje glucosil fosfatidilinositol, desplazan el folato al interior de la célula por medio de endocitosis mediada por los receptores. La tercera proteína, PCFT, transporta el folato en un entorno con pH bajo desde la vesícula al citoplasma celular.
Funciones
Los folatos actúan como coenzimas en la transferencia de unidades de un solo carbono. Dos de estas reacciones intervienen en la síntesis de purina y una en la síntesis de pirimidina necesaria para la replicación de DNA y RNA. El folato también es una coenzima que interviene en la síntesis de metionina.